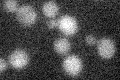
YMR217W
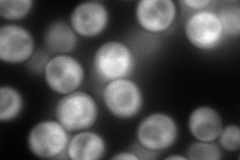
YMR217W
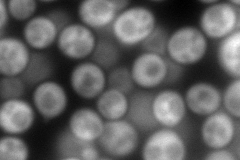
YMR217W
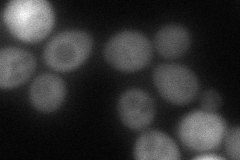
YMR217W
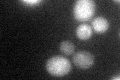
YMR217W
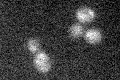
YMR217W

View description
GMP synthase, an enzyme that catalyzes the second step in the biosynthesis of GMP from inosine 5'-phosphate (IMP); transcription is not subject to regulation by guanine but is negatively regulated by nutrient starvation
Localization:
Intensity:
Fold change:
Significance:
-
C’ GFP library in SD
below threshold17.3 -
N' NOP1pr-GFP in SD
cytosol326.42 -
N' TEF2pr-mCherry in SD
cytosol382.039 -
N' NATIVEpr-GFP in SD

cytosol283.028 -
N' TEF2pr-VC and Cyto-VN in SD
cytosol85.4 -
C’ GFP library in SD+DTT
cytosol17.781.02No -
C’ GFP library in SD+H2O2
cytosol15.930.92No -
C’ GFP library in Starvation Media

cytosol13.220.76No -
C’ GFP library on the background of Pup2-DaMP

below threshold -
C’ GFP library on the background of CCT mutant

below threshold20.75731.19954No
